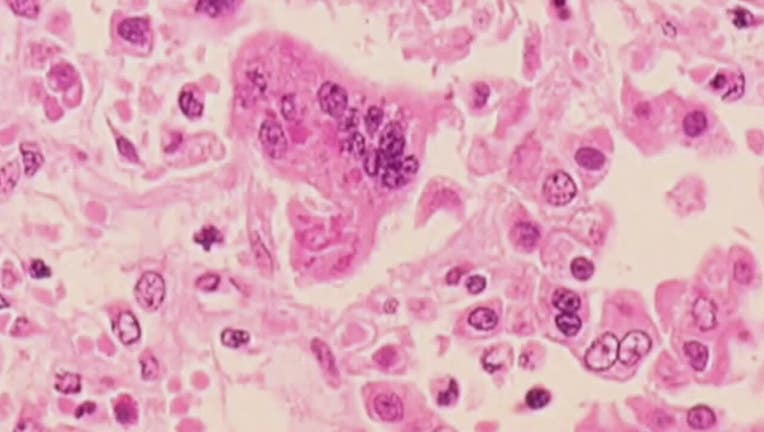

Possible measles exposure: Health officials warn of infected traveler
File photo of measles. (FOX 9)
ROBERTS, Wis. (FOX 9) - An out-of-state traveler may have exposed the public to measles when they visited Wisconsin, according to state health officials.
READ MORE: Wisconsin confirms first 9 measles cases of 2025, all linked to out-of-state travel
Possible Wisconsin measles exposure
What they're saying:
Officials from the Wisconsin Department of Health Services (DHS), as well as officials from the St. Croix County Public Health Department and Rock County Public Health, are warning about a possible measles exposure.
The exposures are believed to have happened at two public locations:
- Flying J Travel Center #470, 1191 70th Ave., Roberts, Wisconsin on Monday, Aug. 4, 2025, between 7:15 a.m. and 10 a.m.
- Pilot Travel Center #289, 3001 Milwaukee Road, Beloit, Wisconsin on Monday, Aug. 4, 2025, between 11:45 a.m. and 2:30 p.m.
Anyone who was at these locations during these times is being asked to check for symptoms and update their immunization status if needed.
DHS states these exposures are unrelated to the nine other cases reported in Wisconsin so far.
The Source: This story uses information shared in a news release from the Wisconsin Department of Health Services.

